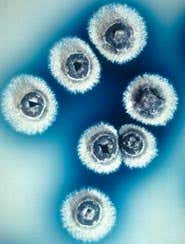
New Scientist. Science news and long reads from expert journalists, covering developments in science, technology, health and the environment on the website and the magazine.

The genome of a potent life-saving bacterium has been fully sequenced, providing invaluable information for scientists rushing to develop new antibiotics.
Streptomyces coelicolor and its relatives produce two-thirds of the natural antibiotics used worldwide as well as anticancer agents and immunosuppressants. The full DNA sequence reveals 22 clusters of genes directly related to antibiotic production – only four were previously known.
The sequence “is a fabulous resource”, says Keith Chater at the John Innes Centre in Norwich, where the S. coelicolor project is based.
Colonies of S. coelicolor secreting the antibiotic actinorhodin (Photo: John Innes Centre)
Advertisement
The increasing resistance of bacteria to antibiotics, including the rise of untreatable superbugs, means new antibiotics are badly needed. The team hopes further work on the 22 gene clusters, and experiments combining these genes with those from other bacteria, should lead to powerful new antibacterials.
“This is a very important day,” says Julius Weinberg, director of the Institute of Health Sciences at City University, London, and an expert on antimicrobial resistance. “The1950s and 1960s were the ‘golden age’ of antibiotic discovery and there was always the feeling you could keep one step ahead of resistance. But that golden age has vanished.”
Selective attack
Streptomyces are common in soil and are responsible for its “earthy” smell. Streptomycin, the first antibiotic produced from the family, appeared in 1944, followed later by key drugs such as tetracycline and erythromycin.
S. coelicolor has 7825 genes among 8.7 million bases – the largest bacterial genome to be fully analysed. This means it is prepared for every eventuality – “the boy scout of bacteria”, says Stephen Bentley at the Wellcome Trust Sanger Centre in Cambridge, which was also involved in the sequencing work.
The bacteria is able to sense chemically what is in the soil around it and selectively express genes to produce enzymes to degrade particular organic remains or to secrete certain antibiotics, to kill competing organisms.
Environmental struggle
Scientists working on new antibiotics should take note, says Weinberg. “Bugs are continually in an environmental struggle. They’re producing chemicals targeted at each other and we should take advantage of that.”
Streptomyces are also important because they are cousins of the bacteria that cause tuberculosis, leprosy and diptheria. Studying common features of the four genomes should lead to insights into new ways to fight the diseases, says David Hopwood of the John Innes Centre.
“For TB, there is a six or 12 month regimen with a cocktail of drugs – and we would have hoped to do better than that,” he says. Multiple drug resistant TB is also an increasing problem worldwide.
Journal reference: Nature (vol 417, p 141)


